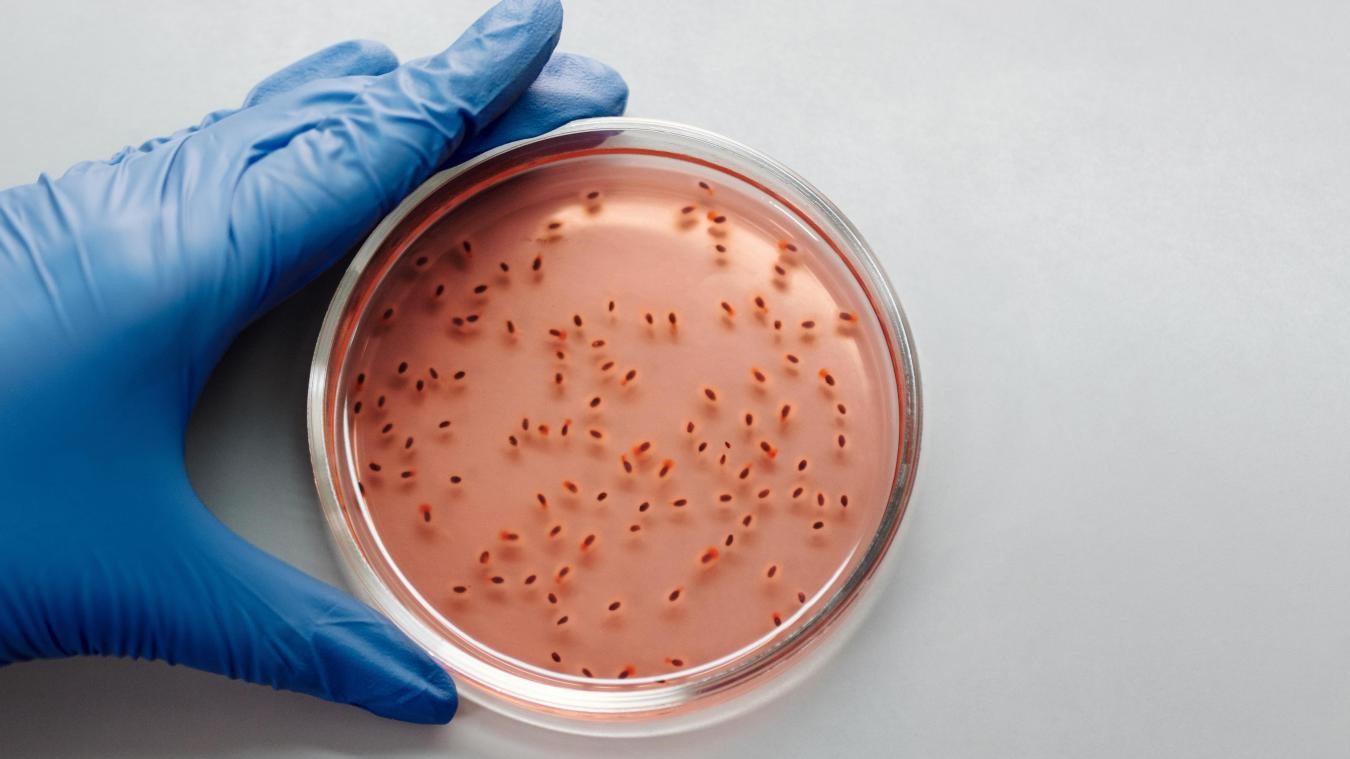

Selon le ministère de la Santé, au 13 juillet, 1.200 cas de cette maladie dites des mains sales, ont été notifiés à Dolisie, avec cinq décès déplorés, six cas, dont un décès, dans le département de Pointe-Noire, et un cas à Brazzaville.
Les pays est en alerte. Dans un communiqué rendu publique le 15 juillet 2023, le gouvernement de la République du Congo indique avoir pris “toutes les dispositions nécessaires” face à une “urgence sanitaire” liée à la montée de cas de shigellose dans le pays. Selon le même communiqué, à la date du 13 juillet, 1.200 cas de shigellose ont été notifiés par les formations sanitaires de la ville de Dolisie, troisième ville congolaise et chef-lieu du département du Niari, avec cinq décès déplorés et un taux de létalité de 0,42%. En plus, six cas, dont un décès, ont été rapportés dans le département de Pointe-Noire, où se trouve la capitale économique du pays, d’après le communiqué, précisant qu’un cas a été notifié à Brazzaville, capitale du pays. « Des échantillons analysés localement ont conclu qu’il s’agit d’une shigellose, dite maladie des mains sales. La confirmation par le Laboratoire national de santé publique est attendue », précise le communiqué. Le texte en question rassure l’opinion de ce que le gouvernement congolais est en train de prendre toutes les dispositions nécessaires pour répondre à cette urgence sanitaire et exhorte la population congolaise à recourir aux services de santé les plus proches, devant tout cas suspect.
Maladie très virulente
En effet, la shigellose, dite maladie des mains sales, dont les causes restent à préciser, se manifeste par la fièvre qui peut aller entre 39 et 40, des céphalées, des douleurs abdominales, des vomissements et asthénie physique. Le processus pathologique induit par Shigella est très rapide. Ces bactéries contiennent un plasmide de virulence et envahissent les cellules épithéliales intestinales puis le tissu constituant la muqueuse recto-colique. Ce processus aboutit à une intense inflammation qui s’accompagne d’une sévère destruction tissulaire. C’est une maladie épidémique contagieuse qui tue environ 200 000 personnes dans le monde par an, dont 65 000 enfants de moins de 5 ans. Au-delà de la mortalité, son haut potentiel épidémique, l’émergence de résistance aux antibiotiques et la morbidité liée aux conséquences à long terme dues à des infections récurrentes constituent un problème majeur de santé publique. La shigellose est par excellence une maladie de l’insuffisance d’hygiène. Les shigelles sont transmises par voie féco-orale. Elles sont extrêmement infectieuses puisque 10 à 100 bacilles suffisent à provoquer la maladie. L’homme est le seul réservoir et peut éliminer ces bactéries dans ses selles pendant des semaines après un épisode dysentérique. A la différence des autres maladies diarrhéiques, la shigellose ne peut être traitée par la seule réhydratation. Les antibiotiques permettent généralement une guérison rapide et sans séquelles. Cependant, le traitement est compliqué par l’émergence de souches multi-résistantes, qui apparaissent fréquemment résistantes à tous les antibiotiques.
Divine KANANYET

Comments are closed